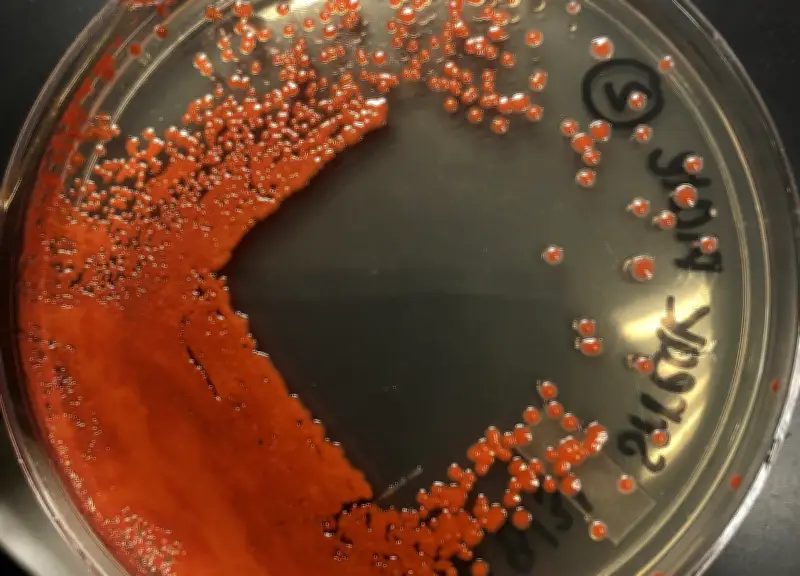
La ciencia detrás de las lágrimas rojas en estatuas religiosas: bacterias, no milagros

El misterio de las lágrimas rojas en imágenes sagradas
Durante siglos, las lágrimas rojas que aparecían en estatuas religiosas fueron interpretadas como señales divinas o milagros sobrenaturales. Estas manifestaciones, que comúnmente se describían como "llanto de sangre", generaban peregrinaciones, devoción y numerosas interpretaciones teológicas. Sin embargo, la ciencia contemporánea ha desvelado una explicación mucho más terrenal para este fenómeno que durante tanto tiempo desconcertó a fieles y curiosos por igual.
La bacteria que pinta de rojo
La protagonista de esta historia es Serratia marcescens, una bacteria que produce un pigmento rojo intenso llamado prodigiosina. Este microorganismo habita en múltiples entornos naturales, especialmente en lugares con humedad, materia orgánica disponible y niveles reducidos de oxígeno. La prodigiosina es tan intensa que puede crear manchas que, a simple vista, se asemejan extraordinariamente a gotas de sangre.
¿Por qué aparece específicamente en estatuas religiosas? La respuesta no tiene nada de místico. Las superficies de estas imágenes suelen presentar pequeñas irregularidades, grietas, poros o relieves que facilitan la acumulación de polvo y materia orgánica. Estos microambientes retienen humedad y reducen la concentración de oxígeno, creando condiciones ideales para el crecimiento de bacterias anaeróbicas o facultativas como la Serratia.
Un fenómeno extendido en la naturaleza
Este fenómeno no es exclusivo de contextos religiosos. En la naturaleza es común observar:
- Manchas de colores intensos en cuerpos de agua
- Superficies rojizas en paredes húmedas
- Coloraciones inusuales en suelos y rocas
Todas estas manifestaciones son producto del crecimiento de microorganismos pigmentados. La diferencia fundamental está en nuestra percepción: mientras que una laguna rojiza se acepta como fenómeno biológico, una mancha similar en una estatua religiosa adquiere connotaciones sobrenaturales.
La psicología detrás de la interpretación
Lo que realmente ocurre es un fenómeno psicológico conocido como sesgo de interés. Los seres humanos prestamos atención selectiva a aquello que nos resulta significativo cultural o emocionalmente. Filtramos la realidad no solo por lo que ocurre, sino especialmente por dónde ocurre. Así, entre miles de eventos cotidianos que pasan desapercibidos, uno adquiere relevancia extraordinaria por su contexto simbólico.
A esto se suma nuestra tendencia natural a buscar patrones y construir narrativas coherentes. Somos expertos en conectar puntos, incluso cuando no forman una figura real. Este mismo mecanismo psicológico explica por qué algunas personas ven predicciones en series animadas o encuentran sentido profundo en coincidencias estadísticamente improbables.
El verdadero milagro de la naturaleza
Quizás la reflexión más profunda que nos deja este descubrimiento científico es que el verdadero milagro no reside en que una estatua llore rojo, sino en que la vida, en sus formas más simples y microscópicas, sea capaz de generar procesos químicos complejos, elegantes y sorprendentes. La capacidad de la Serratia marcescens para producir pigmentos intensos bajo condiciones específicas es, en sí misma, un testimonio de la maravilla de los procesos biológicos.
La próxima vez que escuchemos sobre una imagen religiosa que "llora sangre", podremos recordar que la naturaleza tiene explicaciones fascinantes que no requieren intervención sobrenatural. La ciencia nos permite apreciar la belleza y complejidad del mundo natural, incluso en sus manifestaciones más inesperadas.









